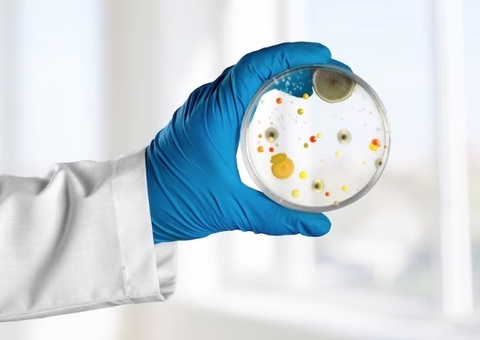
Infecções bacterianas são a segunda principal causa de morte no mundo

Manaus/AM - Com a subida de 1,04 metro do rio Negro, em maio, e atingindo a marca de 28,10 metros, nesta terça-feira (30), a faixa de areia da praia da Ponta Negra fica reduzida com as águas, e a Prefeitura de Manaus reforça as orientações para segurança dos banhistas no período. Uma delas é respeitar as marcações feitas pelos salva-vidas do Corpo de Bombeiros.
Na praia, a orientação para os frequentadores é a proibição do consumo de bebidas em garrafas de vidro; brincar de papagaio (pipa); assim como fazer acampamento. Também é proibido o comércio ambulante não autorizado pela prefeitura. Para a segurança dos banhistas, não é permitido o banho no rio Negro após as 17h, quando se perde mais visibilidade nas águas e não há mais guarda-vidas no complexo.
Para o chefe do Pelotão de Guarda-Vidas, tenente do Corpo de Bombeiros Aluísio Cruz, quem for usar balneário deve atentar para o uso correto e seguro da praia e do banho, além do cuidado com crianças, para que nunca fiquem sozinhas, nem por um instante. “Em razão do volume de frequentadores e com o rio cheio, a responsabilidade deve ser redobrada de pessoas com crianças, para não as perderem de vista”, disse o tenente.
Proibições
Com o aumento de frequentadores nos dias mais quentes, mesmo ainda não sendo o famoso verão amazônico, a coordenação da Ponta Negra alerta para a segurança e o bom uso das instalações, lembrando os itens proibidos no parque. As garrafas de vidro são proibidas na praia por serem perfurocortantes. A orientação é que o público não leve para o espaço garrafas e objetos de vidro ou similares, sob pena de apreensão dos mesmos. A recomendação é que façam uso de garrafas plásticas.
O público é abordado e orientado sobre a apreensão de objetos proibidos. E, as medidas de prevenção devem ser individuais, com a colaboração da população. Na praia e no balneário também não é permitido fazer churrasco ou fogueiras.
Com informações da assessoria

Aviso